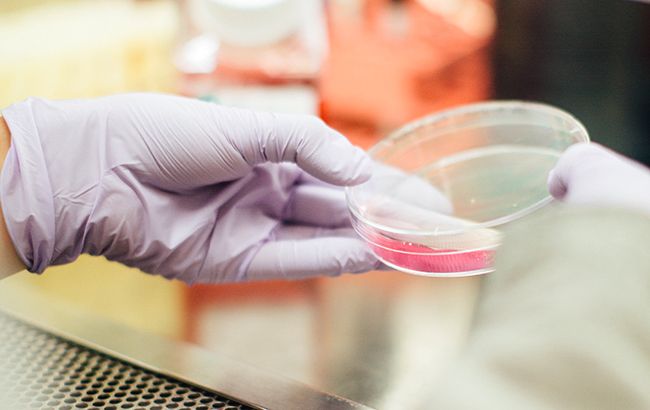
В теле человека обнаружили неизвестный ранее вирус: все детали

В теле человека обнаружили неизвестный ранее вирус: все детали
В теле человека нашли новый вирус (фото: unsplash.com)
В теле человека нашли новый вирус (фото: unsplash.com)
Ученым удалось обнаружить новый вирус, который содержится в теле человека. Этот вид вируса относится к бактериофагам, что размножаются внутри бактерии и вызывают их растворение (лизис).
- Новый штамм ВИЧ: ученые сделали важное заявление
Исследованием занимались специалисты из Университета медицинских наук им. Карла Ландштейнера в Австрии. Ученым удалось выделить 43 вида бактериофагов при исследовании образцов жидкостей, полученных от более ста разных людей.
Один из таких вирусов удалось выявить впервые в истории изучения этого феномена, пишет научный журнал Naked Science.

В теле человека нашли новый вирус (фото: avert.org)
Стоит отметить, что новый вирус был обнаружен в каждом седьмом образце крови, его отнесли к семейству бактериофагов Tunavirinae.
Целью ученых было обнаружение вируса, способного атаковать бактерию кишечной палочки. Но такой выявить не получилось.
Подобные исследования невероятно важны, поскольку эти вирусы влияют на устойчивость организма человека к антибиотикам. Учеными было доказано, что бактериофаги не только повреждают бактерии, но и передают им ген устойчивость к антибактериальным препаратам.

